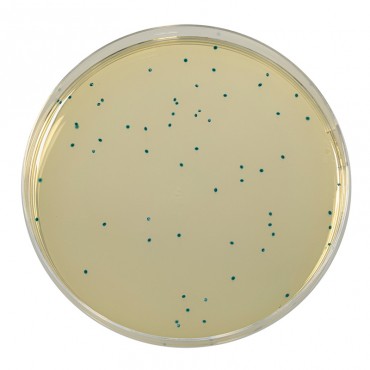

- +Products
- +Allergen testing
- +Culture Media - reagents and reference material
- +Environmental testing solutions
- +Laboratory Consumables
- +Laboratory equipment
- +Microbiology equipment
- +Neogen® Food Safety Solutions
- +Temperature & Humidity Monitoring
- +Services
- SUPPORT
- News
- +About Us
- Contact




COMPASS® Enterococcus Agar
COMPASS® Enterococcus Agar is a selective media used for the enumeration of enterococci in food and water.
Available as dehydrated medium: 500 g bottle
Also available as
- Ready-to-use medium: 20 Petri plates Ø 55 mm (BM15708).
- Ready-to-melt medium: 10 vials of 100 ml (BM11608).
In compliance with regulatory requirements, a USDA permit (VS 16-3) is mandatory for shipments from Canada to the USA due to the inclusion of peptone, an animal byproduct.
Peptones, yeast extract and Tween 80 stimulate the growth of enterococci.
Yeast extract is a source of complex vitamin B.
Sodium chloride maintains the osmotic pressure.
The choice of an incubation temperature at 44 °C, associated with an judicious mixture of inhibitors, allows the high selectivity of the media and the inhibition of contaminating microflora.
The X-β-glucoside insures the chromogenic revelation of the β-glucosidase activity of the enterococci. These colonies present a blue coloration after hydrolysis of the substrate (5-bromo-4-chloro-3-indolyl-β-D-glucoside).
Related Products